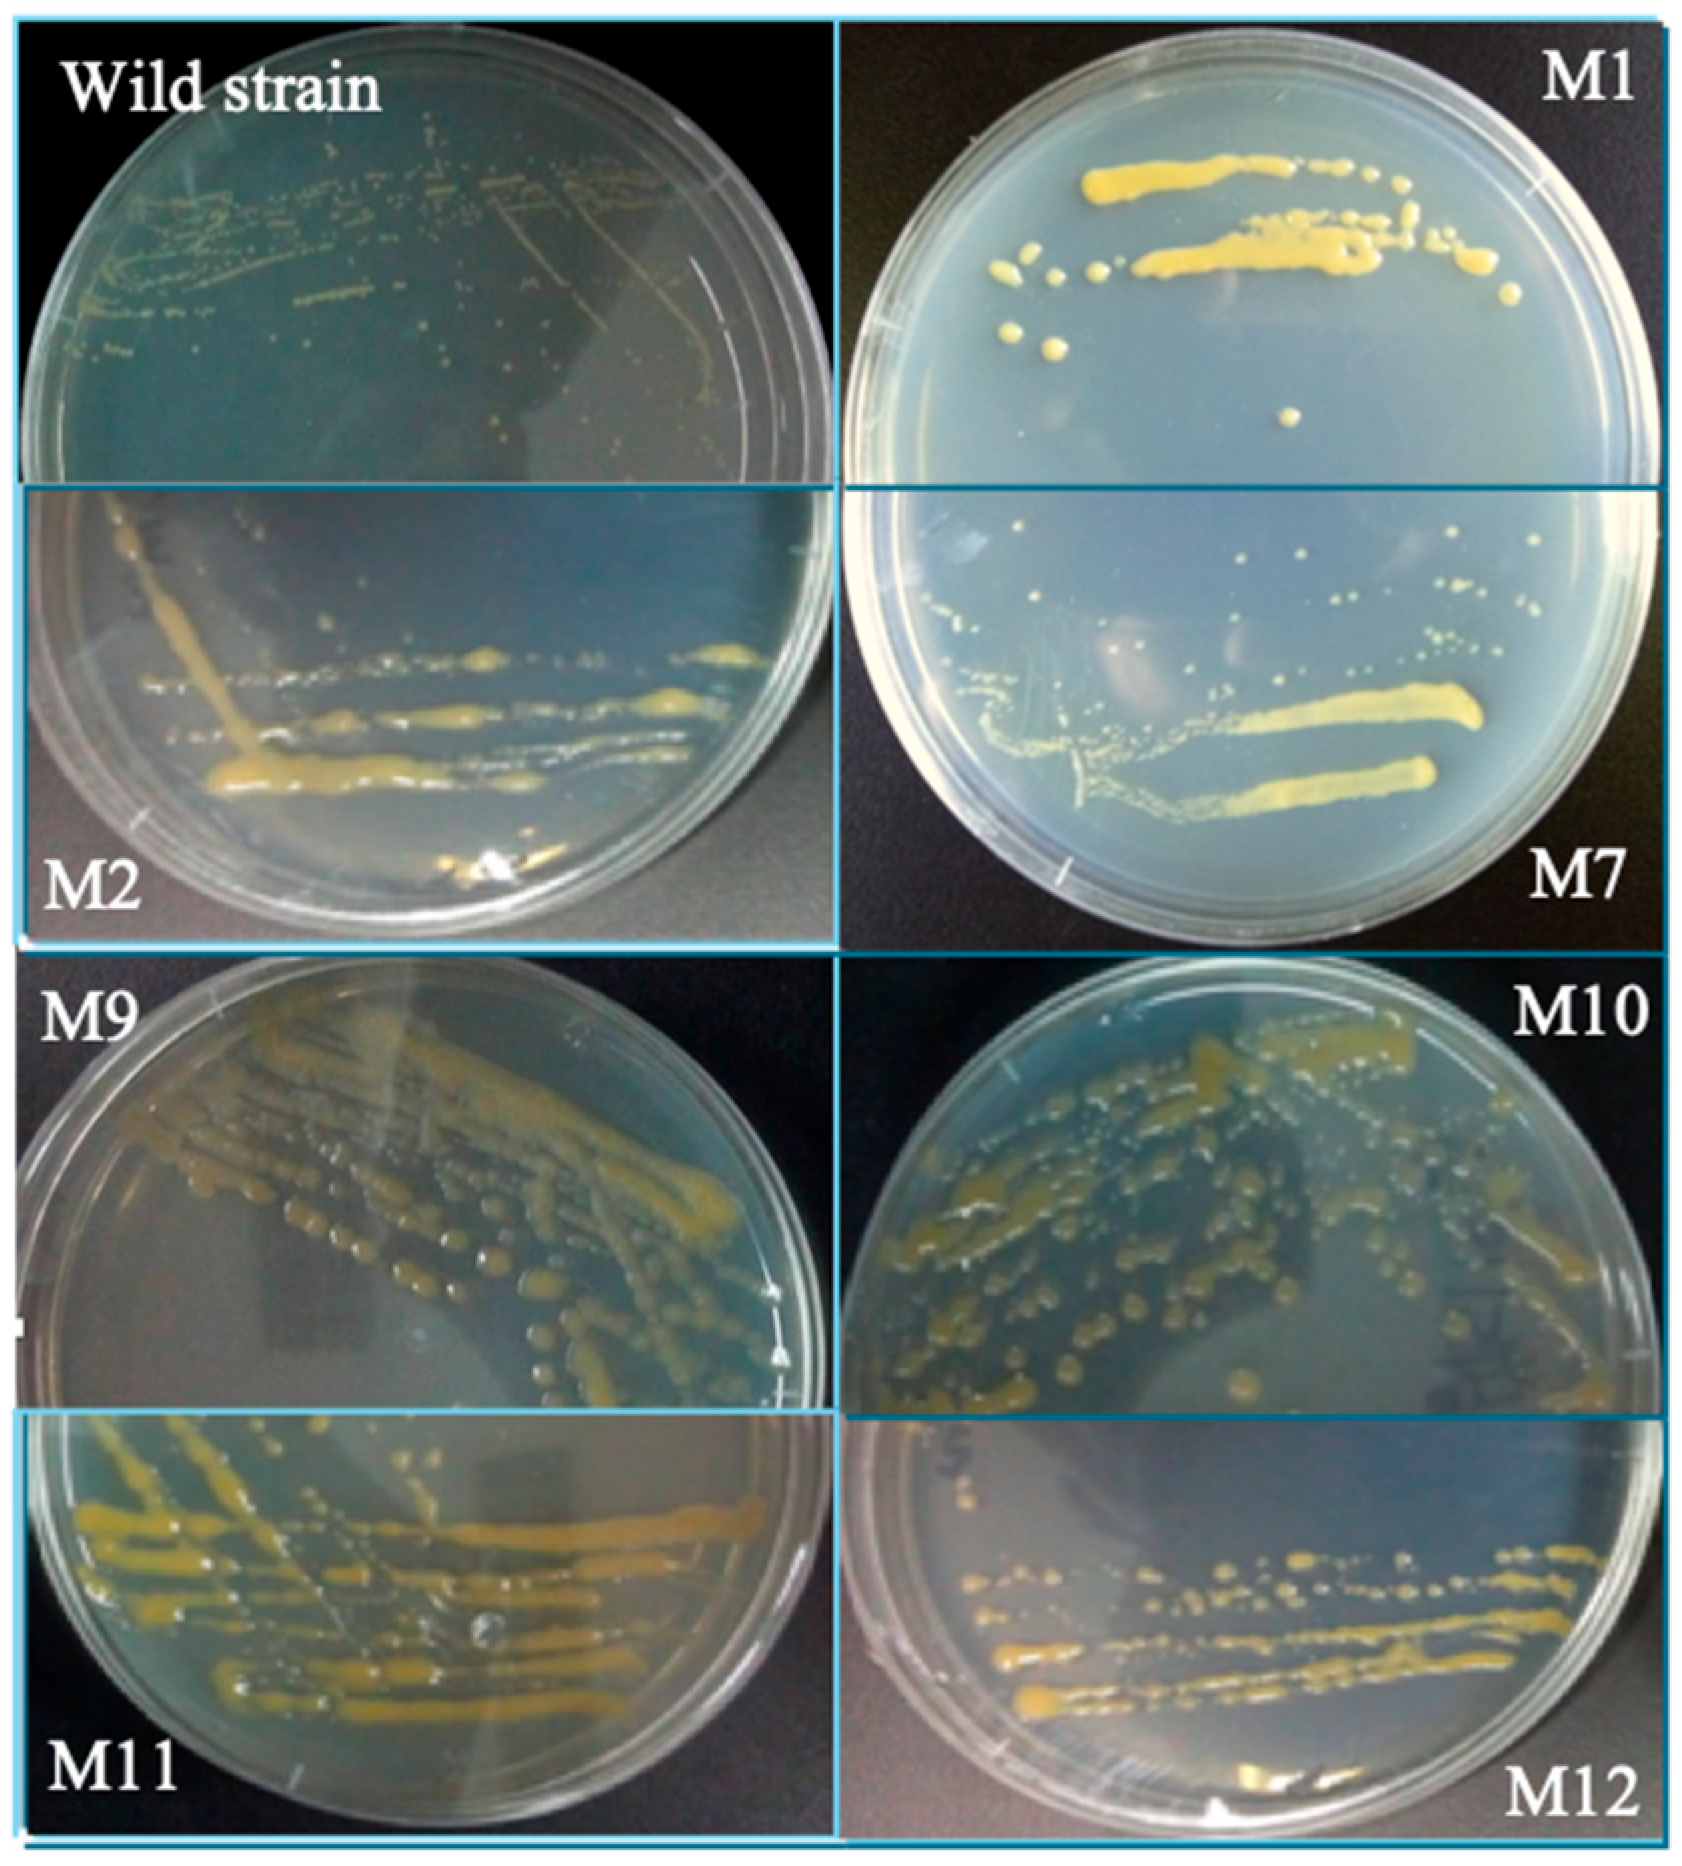
Ijms 26 06756 g003

Correction: Liu et al. Mutation Breeding of Extracellular Polysaccharide-Producing Microalga Crypthecodinium cohnii by a Novel Mutagenesis with Atmospheric and Room Temperature Plasma. Int. J. Mol. Sci. 2015, 16, 8201–8212
Reference
- Liu, B.; Sun, Z.; Ma, X.; Yang, B.; Jiang, Y.; Wei, D.; Chen, F. Mutation Breeding of Extracellular Polysaccharide-Producing Microalga Crypthecodinium cohnii by a Novel Mutagenesis with Atmospheric and Room Temperature Plasma. Int. J. Mol. Sci. 2015, 16, 8201–8212. [Google Scholar] [CrossRef] [PubMed]
Disclaimer/Publisher’s Note: The statements, opinions and data contained in all publications are solely those of the individual author(s) and contributor(s) and not of MDPI and/or the editor(s). MDPI and/or the editor(s) disclaim responsibility for any injury to people or property resulting from any ideas, methods, instructions or products referred to in the content. |
© 2025 by the authors. Licensee MDPI, Basel, Switzerland. This article is an open access article distributed under the terms and conditions of the Creative Commons Attribution (CC BY) license (https://creativecommons.org/licenses/by/4.0/).
Share and Cite
Liu, B.; Sun, Z.; Ma, X.; Yang, B.; Jiang, Y.; Wei, D.; Chen, F. Correction: Liu et al. Mutation Breeding of Extracellular Polysaccharide-Producing Microalga Crypthecodinium cohnii by a Novel Mutagenesis with Atmospheric and Room Temperature Plasma. Int. J. Mol. Sci. 2015, 16, 8201–8212. Int. J. Mol. Sci. 2025, 26, 6756. https://doi.org/10.3390/ijms26146756
Liu B, Sun Z, Ma X, Yang B, Jiang Y, Wei D, Chen F. Correction: Liu et al. Mutation Breeding of Extracellular Polysaccharide-Producing Microalga Crypthecodinium cohnii by a Novel Mutagenesis with Atmospheric and Room Temperature Plasma. Int. J. Mol. Sci. 2015, 16, 8201–8212. International Journal of Molecular Sciences. 2025; 26(14):6756. https://doi.org/10.3390/ijms26146756
Chicago/Turabian StyleLiu, Bin, Zheng Sun, Xiaonian Ma, Bo Yang, Yue Jiang, Dong Wei, and Feng Chen. 2025. "Correction: Liu et al. Mutation Breeding of Extracellular Polysaccharide-Producing Microalga Crypthecodinium cohnii by a Novel Mutagenesis with Atmospheric and Room Temperature Plasma. Int. J. Mol. Sci. 2015, 16, 8201–8212" International Journal of Molecular Sciences 26, no. 14: 6756. https://doi.org/10.3390/ijms26146756
APA StyleLiu, B., Sun, Z., Ma, X., Yang, B., Jiang, Y., Wei, D., & Chen, F. (2025). Correction: Liu et al. Mutation Breeding of Extracellular Polysaccharide-Producing Microalga Crypthecodinium cohnii by a Novel Mutagenesis with Atmospheric and Room Temperature Plasma. Int. J. Mol. Sci. 2015, 16, 8201–8212. International Journal of Molecular Sciences, 26(14), 6756. https://doi.org/10.3390/ijms26146756

